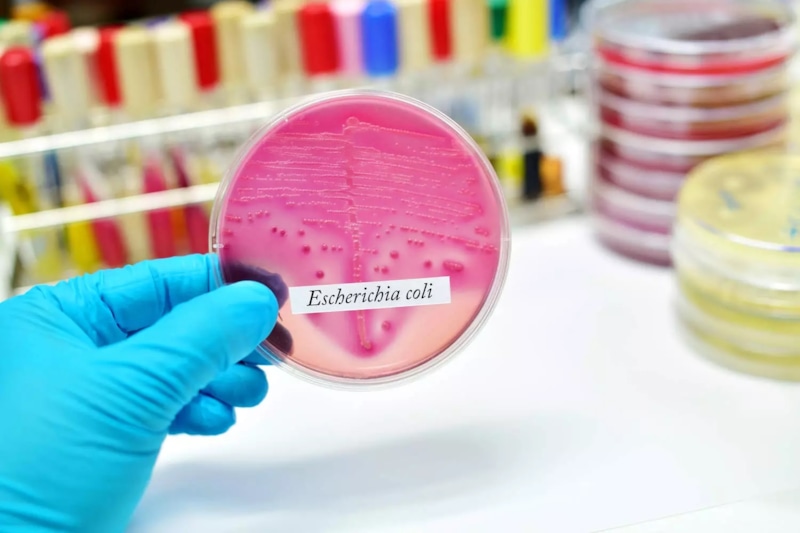
Опасность изнутри организма: кишечная палочка и инфекция Опасность изнутри организма: кишечная палочка и инфекция

Осторожно — инфекции мочевыводящих путей: как кишечная палочка из мяса провоцирует ИМП у женщин
Люди нередко страдают от инфекций мочевыводящих путей (ИМП), вызванных переохлаждением, снижением иммунитета и бактериями. Эксперты издания Daily Mail отмечают, что причина большинства ИМП – кишечная палочка (Escherichia coli), бактерия, обитающая в кишечнике.
Она безвредна, но до тех пор, пока не попадет в мочевыводящие пути. Симптомы заражения включают проблемы с мочеиспусканием, повышение температуры тела, боль в области таза и жжение. Если же Escherichia coli попадает в кровь, то развивается опасное для жизни состояние – сепсис.
Факторы риска
Кишечная палочка способна распространяться при незащищенном половом контакте и немытых руках. Женщины чаще подвергаются риску из-за особенностей строения: их мочевыводящие пути короче и расположены ближе к кишечнику, что упрощает передачу бактерий.
Недавние медицинские исследования выявили новую, упускаемую из виду причину. Это диета, в том числе сырое мясо.
Во время приготовления пищи бактерии переносятся на руки и рабочие поверхности, в итоге попадая в организм человека. Так в кишечник к уже имеющимся добавляются потенциально более устойчивые штаммы кишечной палочки.
Результаты исследования
Исследование с участием 23 483 человек показало, что каждая пятая инфекция мочевыводящих путей напрямую связана с употреблением мяса и птицы. Эта корреляция дополнительно подтверждается данными, показывающими, что у вегетарианцев вероятность развития инфекций мочевыводящих путей на 18% ниже. Поэтому сокращение потребления мяса становится полезной профилактической мерой.
Полезно знать
Большинство штаммов кишечной палочки (E. coli) безвредны. Они помогают выработке витамина К2, необходимого для свертывания крови и здоровья костей. Кроме того, они предотвращают развитие в кишечнике вредных патогенов, которые конкурируют с полезными бактериями за питательные вещества.
Однако отдельные патогенные штаммы E. coli вызывают серьезные болезни. Например, энтерогеморрагическая кишечная палочка продуцирует токсин Шига, способный привести к сильной диарее с кровью и почечной недостаточности.
Другие штаммы вызывают инфекции мочевыводящих путей или проблемы с дыханием. Эти опасные бактерии передаются через зараженную пищу, непастеризованное молоко или небезопасную питьевую воду.
Данный материал носит информационный характер и не является рекомендацией к применению. Требуется консультация специалиста.